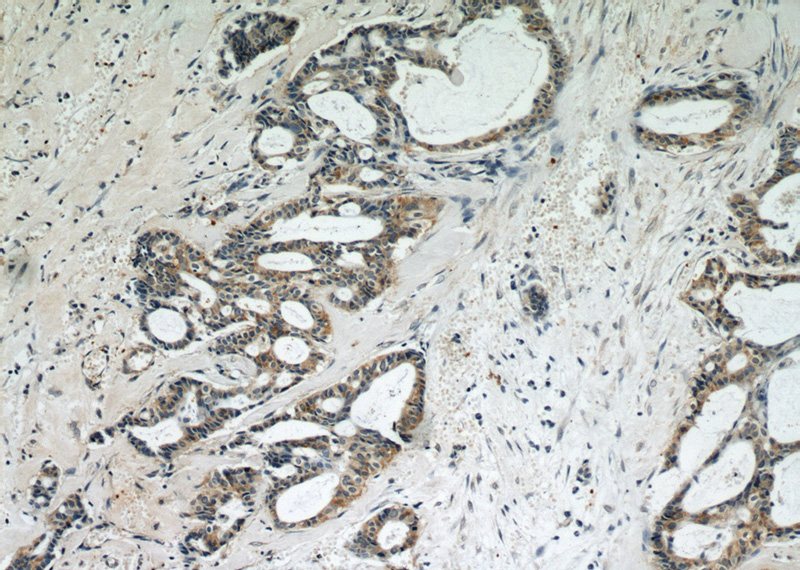
Immunohistochemical of paraffin-embedded human breast cancer using Catalog No:115290(SKP2 antibody) at dilution of 1:50 (under 10x lens)
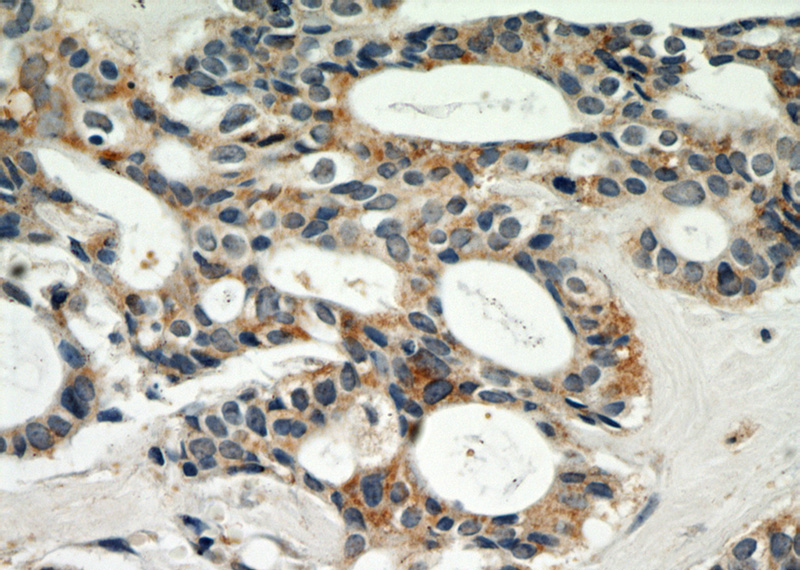
Immunohistochemical of paraffin-embedded human breast cancer using Catalog No:115290(SKP2 antibody) at dilution of 1:50 (under 40x lens)

-
Product Name
SKP2 antibody
- Documents
-
Description
SKP2 Rabbit Polyclonal antibody. Positive WB detected in HEK-293 cells, Jurkat cells. Positive IP detected in HEK-293 cells. Positive IF detected in HepG2 cells. Positive IHC detected in human breast cancer tissue. Observed molecular weight by Western-blot: 48kd
-
Tested applications
ELISA, IHC, WB, IP, IF
-
Species reactivity
Human,Mouse,Rat; other species not tested.
-
Alternative names
F box protein Skp2 antibody; F box/LRR repeat protein 1 antibody; FBL1 antibody; FBXL1 antibody; FLB1 antibody; p45skp2 antibody; SKP2 antibody
-
Isotype
Rabbit IgG
-
Preparation
This antibody was obtained by immunization of SKP2 recombinant protein (Accession Number: NM_032637). Purification method: Antigen affinity purified.
-
Clonality
Polyclonal
-
Formulation
PBS with 0.02% sodium azide and 50% glycerol pH 7.3.
-
Storage instructions
Store at -20℃. DO NOT ALIQUOT
-
Applications
Recommended Dilution:
WB: 1:200-1:2000
IP: 1:200-1:1000
IHC: 1:20-1:200
IF: 1:10-1:100
-
Validations
Immunohistochemical of paraffin-embedded human breast cancer using Catalog No:115290(SKP2 antibody) at dilution of 1:50 (under 10x lens)
Immunohistochemical of paraffin-embedded human breast cancer using Catalog No:115290(SKP2 antibody) at dilution of 1:50 (under 40x lens)

HEK-293 cells were subjected to SDS PAGE followed by western blot with Catalog No:115290(SKP2 Antibody) at dilution of 1:600

IP Result of anti-SKP2 (IP:Catalog No:115290, 4ug; Detection:Catalog No:115290 1:300) with HEK-293 cells lysate 2440ug.

Immunofluorescent analysis of HepG2 cells using Catalog No:115290(SKP2 Antibody) at dilution of 1:25 and Alexa Fluor 488-congugated AffiniPure Goat Anti-Rabbit IgG(H+L)
-
Background
SKP2(S-phase kinase-associated protein 2) is also named as FBXL1 and belongs to the F-box family. It regulates cellular proliferation by targeting several cell cycle-regulated proteins for ubiquitination and degradation, including cyclin-dependent kinase inhibitor CDKN1B(PMID:22200179). The acetylation of SKP2 in the nuclear localization signal (NLS) can promote its cytoplasmic retention, and cytoplasmic SKP2 enhances cellular migration through ubiquitination and destruction of CDH. This protein has 3 isoforms produced by alternative splicing.
-
References
- Wu H, Xiao Y, Zhang S. The Ets transcription factor GABP is a component of the hippo pathway essential for growth and antioxidant defense. Cell reports. 3(5):1663-77. 2013.
- Su H, Wan Q, Tian XJ. MAD2B contributes to podocyte injury of diabetic nephropathy via inducing cyclin B1 and Skp2 accumulation. American journal of physiology. Renal physiology. 308(7):F728-36. 2015.
Related Products / Services
Please note: All products are "FOR RESEARCH USE ONLY AND ARE NOT INTENDED FOR DIAGNOSTIC OR THERAPEUTIC USE"
